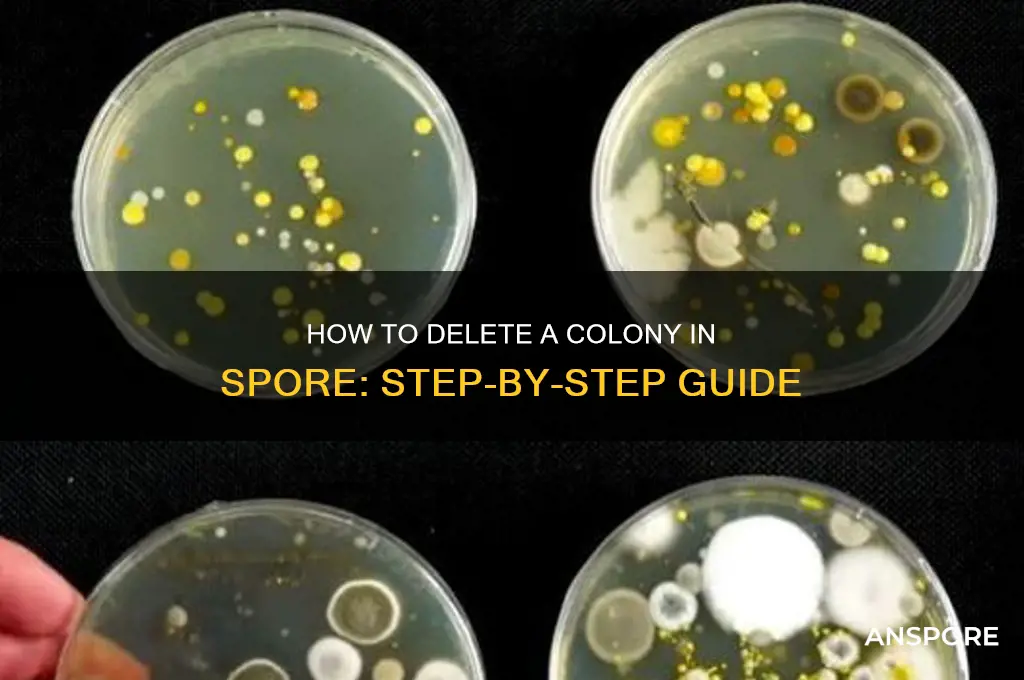
how do i delete a colony in spore

In *Spore*, deleting a colony is a straightforward process that allows players to manage their empire more efficiently. Whether you’re looking to reclaim resources, reorganize your civilization, or simply remove an unwanted settlement, the game provides a clear method to achieve this. By accessing the city view of the colony you wish to delete, you can locate the option to dismantle or abandon it, typically found in the city management menu. This action will remove the colony from the planet, freeing up space and resources for other purposes. Understanding how to delete a colony is essential for players aiming to optimize their galactic strategy and maintain control over their expanding empire.
| Characteristics | Values |
|---|---|
| Game | Spore |
| Platform | PC, Mac, iOS, Android |
| Colony Deletion Method | 1. Select the colony you want to delete. 2. Click on the "Destroy" button (represented by a red circle with a line through it). 3. Confirm the deletion by clicking "Yes" in the pop-up window. |
| Alternative Method (PC/Mac) | 1. Press and hold the "Shift" key. 2. Right-click on the colony you want to delete. 3. Select "Destroy" from the context menu. |
| Note | Destroying a colony will remove all buildings, vehicles, and creatures associated with it. This action is irreversible. |
| Game Stage | Civilization Stage |
| Requirement | The colony must be under your control (i.e., you must have founded it or conquered it). |
| Consequence | Destroying a colony will reduce your empire's overall score and may impact your relationships with other civilizations. |
| Tooltip | "Destroy this colony and all its contents" |
| Confirmation Prompt | "Are you sure you want to destroy this colony? This action cannot be undone." |
| Shortcut Key (PC/Mac) | Shift + Right-click |
| Mobile Controls | Tap and hold on the colony, then select the "Destroy" option from the radial menu. |
| Game Version | All versions (as of 2023) |
| Developer | Maxis |
| Publisher | Electronic Arts |
| Release Date | 2008 (PC/Mac), 2009 (iOS), 2010 (Android) |
Explore related products
What You'll Learn

Accessing the Colony Menu
To delete a colony in *Spore*, you must first navigate to the Colony Menu, a central hub for managing your civilization’s settlements. This menu is not immediately obvious, as it requires a specific interaction within the game’s interface. Players often overlook the small, unassuming icon located in the bottom-right corner of the screen during the Civilization stage. This icon, resembling a cityscape, is your gateway to colony management. Clicking it reveals a detailed overview of your colonies, including population, health, and resource production—critical information for making informed decisions about which colonies to maintain or remove.
The process of accessing the Colony Menu is straightforward but demands attention to detail. Begin by ensuring you are in the Civilization stage, as this menu is exclusive to this phase of the game. Once confirmed, locate the cityscape icon and click it to open the menu. Here, you’ll find a list of all your colonies, each represented by a thumbnail image and key statistics. This layout is designed for efficiency, allowing you to quickly assess which colonies are thriving and which are underperforming. For players aiming to streamline their empire, this menu is indispensable.
One common mistake players make is confusing the Colony Menu with the Spacecraft Editor or the Tribal Stage interface. The Colony Menu is unique to the Civilization stage and serves a distinct purpose: managing settlements rather than vehicles or tribes. To avoid confusion, remember that the cityscape icon is your sole entry point to this menu. If you find yourself in the wrong interface, simply exit and look for the correct icon in the bottom-right corner. This clarity ensures you spend less time navigating and more time strategizing.
For players seeking to delete a colony, accessing the Colony Menu is only the first step. Once inside, you’ll need to select the colony you wish to remove and confirm the action. However, the menu’s true value lies in its ability to provide context for your decision. By analyzing each colony’s performance metrics, you can make data-driven choices rather than relying on guesswork. For instance, a colony with low health and dwindling resources may be a prime candidate for deletion, freeing up assets for more productive settlements.
In summary, accessing the Colony Menu in *Spore* is a simple yet crucial skill for effective civilization management. By familiarizing yourself with the cityscape icon and understanding the menu’s layout, you can efficiently evaluate and delete underperforming colonies. This process not only optimizes your empire but also enhances your overall gameplay experience. Mastery of this menu is a hallmark of a strategic player, turning raw data into actionable decisions.
Are C. Diff Spores Everywhere? Uncovering the Hidden Truth
You may want to see also

Selecting the Colony to Delete
In the intricate world of *Spore*, managing your galactic empire requires strategic decision-making, especially when it comes to deleting a colony. The first and most critical step is selecting the right colony to remove. This choice should not be taken lightly, as it impacts your empire’s resources, influence, and overall stability. Begin by assessing each colony’s value: consider its resource output, strategic location, and alignment with your long-term goals. A colony on a planet rich in spices, for instance, might be more valuable than one on a barren world, unless the latter serves as a crucial military outpost.
Analytically, the selection process involves weighing opportunity costs. Deleting a colony frees up a slot for a new one, potentially on a more resource-rich planet. However, dismantling an established colony means losing its accumulated wealth, relationships with neighboring empires, and any unique bonuses it provides. For example, a colony with high culture output might be worth preserving if you’re aiming to win the game through cultural dominance. Conversely, a colony that’s constantly under attack or draining your resources may be a prime candidate for deletion, especially if its strategic value is minimal.
From a practical standpoint, the interface in *Spore* simplifies this decision by displaying key metrics for each colony. Look for indicators like population, happiness, and resource production. A colony with low happiness and declining population is often a red flag, signaling inefficiency or mismanagement. However, don’t overlook colonies that seem stable but contribute little to your empire’s growth. Sometimes, a seemingly successful colony may be occupying a slot that could be better utilized elsewhere.
Persuasively, consider the emotional and narrative aspects of your empire. While *Spore* is a game of strategy, it also allows for personal storytelling. If a colony holds sentimental value—perhaps it was your first interstellar settlement—think twice before deleting it. On the other hand, if a colony has become a liability or no longer aligns with your vision for your empire, removing it can be a bold, necessary step toward progress. Remember, the goal is not just survival but thriving in a competitive galaxy.
In conclusion, selecting the colony to delete in *Spore* requires a blend of analytical thinking, practical evaluation, and strategic foresight. By carefully assessing each colony’s value, understanding the opportunity costs, and considering both practical and emotional factors, you can make an informed decision that strengthens your empire. This process is not just about removal but about optimization, ensuring every colony contributes meaningfully to your galactic legacy.
Norovirus Spores: Fact or Fiction? Unraveling the Truth About Transmission
You may want to see also

Confirming Deletion Prompt
In Spore, deleting a colony is a permanent action that requires careful consideration. The game’s interface includes a Confirming Deletion Prompt to ensure players don’t accidentally erase their progress. This prompt typically appears as a pop-up message asking, “Are you sure you want to delete this colony?” It serves as a final checkpoint, giving players a moment to reconsider before committing to the irreversible action. This design choice reflects the game’s emphasis on player agency while minimizing the risk of unintended consequences.
Analyzing the Confirming Deletion Prompt reveals its dual purpose: prevention and education. By forcing players to actively confirm deletion, the prompt reduces the likelihood of accidental loss. It also subtly educates players about the gravity of their decision, reinforcing the idea that colonies are valuable assets within the game’s ecosystem. This is particularly important in Spore, where colonies contribute to a player’s overall success and influence in the galactic stage. The prompt acts as a safeguard, balancing gameplay freedom with the need for thoughtful decision-making.
From a practical standpoint, the Confirming Deletion Prompt is straightforward but requires attention. Players must read the message carefully and select the appropriate option to proceed. For example, if you’re managing multiple colonies and decide to delete one, the prompt will appear immediately after selecting the “Delete Colony” button. To avoid mistakes, ensure you’re deleting the correct colony by double-checking its name or location before confirming. This small step can save hours of rebuilding and re-establishing a lost colony.
Comparatively, Spore’s approach to deletion prompts differs from other strategy games, where such actions are often immediate or lack confirmation. Games like *Civilization* or *SimCity* may allow players to undo certain decisions, but Spore’s permanence aligns with its evolutionary and survival themes. The Confirming Deletion Prompt thus becomes a critical tool for players navigating the game’s complexities. It encourages a more deliberate playstyle, aligning with Spore’s broader focus on long-term planning and resource management.
In conclusion, the Confirming Deletion Prompt in Spore is more than a mere interface element—it’s a strategic safeguard. By requiring explicit confirmation, it protects players from hasty decisions while emphasizing the importance of each colony. Whether you’re a seasoned player or new to the game, understanding and respecting this prompt ensures a smoother, more intentional gameplay experience. Always take a moment to confirm your choice, as the consequences of deletion are as final as they are impactful.
Elevators' Role in Fungal Spores Dispersal: A Hidden Mechanism Explained
You may want to see also
Explore related products

Post-Deletion Resource Changes
Deleting a colony in Spore triggers a cascade of resource adjustments that can significantly impact your gameplay strategy. Understanding these changes is crucial for minimizing losses and maximizing efficiency in your intergalactic empire. Upon deletion, all resources allocated to the colony, including spice, energy, and trade goods, are immediately forfeited. This means that carefully planned investments in infrastructure and population growth vanish, leaving a noticeable dent in your overall resource pool.
The impact extends beyond the immediate loss. The colony's contribution to your empire's spice income ceases, affecting your ability to fund further colonization efforts or upgrade existing colonies. This sudden drop in spice production can disrupt your long-term expansion plans, forcing you to reallocate resources from other colonies or slow down your galactic conquest.
The game's resource distribution algorithm also undergoes a recalibration after colony deletion. The remaining colonies may experience a slight increase in resource output as the game attempts to balance the overall resource flow. However, this adjustment is often insufficient to fully compensate for the loss of the deleted colony, highlighting the importance of strategic planning and resource diversification.
To mitigate the negative effects of post-deletion resource changes, consider implementing a contingency plan. Prioritize establishing multiple spice-rich colonies to ensure a steady income stream even if one colony is lost. Diversifying your resource base by investing in energy production and trade networks can also provide a safety net during times of resource scarcity. Additionally, maintaining a reserve of spice can help bridge the gap until your remaining colonies can compensate for the loss.
In conclusion, deleting a colony in Spore is not a decision to be taken lightly. The resulting resource changes can have far-reaching consequences, affecting your empire's growth and stability. By understanding the mechanics of post-deletion resource adjustments and implementing strategic countermeasures, players can navigate this challenge and continue their galactic domination with minimal setbacks. Remember, in the vastness of space, foresight and adaptability are key to building an enduring empire.
Mold Spores and Bacterial Infections: Unraveling the Hidden Health Risks
You may want to see also

Impact on Empire Progression
Deleting a colony in Spore is a strategic decision that can significantly influence the progression of your empire. While it may seem counterintuitive to abandon a settlement, this action can free up resources and refocus your efforts on more critical areas. For instance, if a colony is underperforming due to poor location or resource scarcity, removing it allows you to reallocate its upkeep costs to more productive ventures, such as upgrading existing colonies or funding military campaigns. This tactical pruning ensures your empire remains efficient and competitive in the interstellar landscape.
The impact of deleting a colony extends beyond immediate resource management; it also affects your empire’s diplomatic and territorial standing. Abandoning a colony can create a power vacuum, potentially inviting rival empires to claim the territory. To mitigate this, time the deletion strategically—for example, during periods of peace or when your military strength is at its peak. Additionally, consider negotiating with neighboring empires to ensure they do not exploit the vacated space. This foresight preserves your empire’s influence and minimizes the risk of territorial disputes.
From a long-term progression standpoint, deleting a colony can accelerate your empire’s technological and economic growth. By eliminating a drain on resources, you can invest more heavily in research, city development, or trade routes. For example, redirecting the 500 energy units previously spent on a struggling colony into a space station upgrade can double your trade income within a few game cycles. This shift in focus ensures your empire remains on the cutting edge of development, outpacing competitors in both innovation and wealth.
However, deleting a colony is not without its risks. It reduces your empire’s population cap, which can slow down the growth of your cities and military forces. To counteract this, ensure your remaining colonies are optimized for population growth—for example, by placing entertainment buildings or increasing health coverage. Pairing colony deletion with targeted investments in high-performing settlements can maintain a balanced and thriving empire. This approach transforms a seemingly destructive act into a catalyst for sustained progression.
Troubleshooting Spore Registration Issues on Origin: A Comprehensive Guide
You may want to see also
Frequently asked questions
To delete a colony in Spore, enter the Space Stage, select the planet with the colony you want to remove, and use the "Eradicate" tool to destroy the city. This will effectively delete the colony.
Yes, deleting a colony by eradicating it will not harm your empire, but it will remove the colony's contributions to your spice or health. Be cautious, as losing colonies can impact your resources.
No, the Eradicate tool is the only in-game method to delete a colony. You cannot remove a colony through other means, such as abandoning it or relocating it.

























